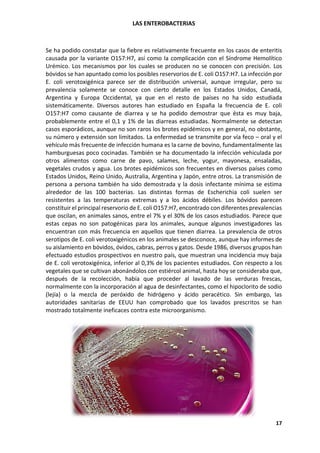
LAS ENTEROBACTERIAS
17
Se ha podido constatar que la fiebre es relativamente frecuente en los casos de enteritis
causada por la variante O157:H7, así como la complicación con el Síndrome Hemolítico
Urémico. Los mecanismos por los cuales se producen no se conocen con precisión. Los
bóvidos se han apuntado como los posibles reservorios de E. coli O157:H7. La infección por
E. coli verotoxigénica parece ser de distribución universal, aunque irregular, pero su
prevalencia solamente se conoce con cierto detalle en los Estados Unidos, Canadá,
Argentina y Europa Occidental, ya que en el resto de países no ha sido estudiada
sistemáticamente. Diversos autores han estudiado en España la frecuencia de E. coli
O157:H7 como causante de diarrea y se ha podido demostrar que ésta es muy baja,
probablemente entre el 0,1 y 1% de las diarreas estudiadas. Normalmente se detectan
casos esporádicos, aunque no son raros los brotes epidémicos y en general, no obstante,
su número y extensión son limitados. La enfermedad se transmite por vía feco – oral y el
vehículo más frecuente de infección humana es la carne de bovino, fundamentalmente las
hamburguesas poco cocinadas. También se ha documentado la infección vehiculada por
otros alimentos como carne de pavo, salames, leche, yogur, mayonesa, ensaladas,
vegetales crudos y agua. Los brotes epidémicos son frecuentes en diversos países como
Estados Unidos, Reino Unido, Australia, Argentina y Japón, entre otros. La transmisión de
persona a persona también ha sido demostrada y la dosis infectante mínima se estima
alrededor de las 100 bacterias. Las distintas formas de Escherichia coli suelen ser
resistentes a las temperaturas extremas y a los ácidos débiles. Los bóvidos parecen
constituir el principal reservorio de E. coli O157:H7, encontrado con diferentes prevalencias
que oscilan, en animales sanos, entre el 7% y el 30% de los casos estudiados. Parece que
estas cepas no son patogénicas para los animales, aunque algunos investigadores las
encuentran con más frecuencia en aquellos que tienen diarrea. La prevalencia de otros
serotipos de E. coli verotoxigénicos en los animales se desconoce, aunque hay informes de
su aislamiento en bóvidos, óvidos, cabras, perros y gatos. Desde 1986, diversos grupos han
efectuado estudios prospectivos en nuestro país, que muestran una incidencia muy baja
de E. coli verotoxigénica, inferior al 0,3% de los pacientes estudiados. Con respecto a los
vegetales que se cultivan abonándolos con estiércol animal, hasta hoy se consideraba que,
después de la recolección, había que proceder al lavado de las verduras frescas,
normalmente con la incorporación al agua de desinfectantes, como el hipoclorito de sodio
(lejía) o la mezcla de peróxido de hidrógeno y ácido peracético. Sin embargo, las
autoridades sanitarias de EEUU han comprobado que los lavados prescritos se han
mostrado totalmente ineficaces contra este microorganismo.
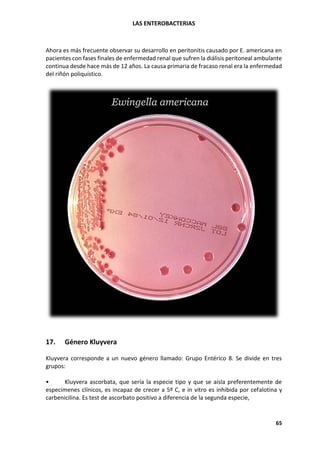
LAS ENTEROBACTERIAS
65
Ahora es más frecuente observar su desarrollo en peritonitis causado por E. americana en
pacientes con fases finales de enfermedad renal que sufren la diálisis peritoneal ambulante
continua desde hace más de 12 años. La causa primaria de fracaso renal era la enfermedad
del riñón poliquístico.
17. Género Kluyvera
Kluyvera corresponde a un nuevo género llamado: Grupo Entérico 8. Se divide en tres
grupos:
• Kluyvera ascorbata, que sería la especie tipo y que se aísla preferentemente de
especímenes clínicos, es incapaz de crecer a 5º C, e in vitro es inhibida por cefalotina y
carbenicilina. Es test de ascorbato positivo a diferencia de la segunda especie,
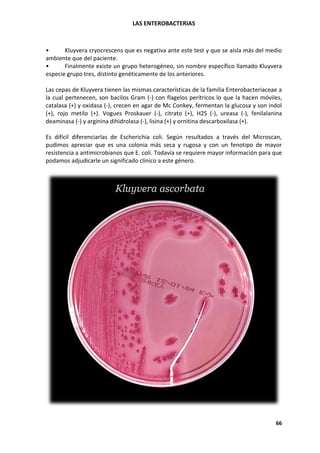
LAS ENTEROBACTERIAS
66
• Kluyvera cryocrescens que es negativa ante este test y que se aísla más del medio
ambiente que del paciente.
• Finalmente existe un grupo heterogéneo, sin nombre específico llamado Kluyvera
especie grupo tres, distinto genéticamente de los anteriores.
Las cepas de Kluyvera tienen las mismas características de la familia Enterobacteriaceae a
la cual pertenecen, son bacilos Gram (-) con flagelos perítricos lo que la hacen móviles,
catalasa (+) y oxidasa (-), crecen en agar de Mc Conkey, fermentan la glucosa y son indol
(+), rojo metilo (+). Vogues Proskauer (-), citrato (+), H2S (-), ureasa (-), fenilalanina
deaminasa (-) y arginina dihidrolasa (-), lisina (+) y ornitina descarboxilasa (+).
Es difícil diferenciarlas de Escherichia coli. Según resultados a través del Microscan,
pudimos apreciar que es una colonia más seca y rugosa y con un fenotipo de mayor
resistencia a antimicrobianos que E. coli. Todavía se requiere mayor información para que
podamos adjudicarle un significado clínico a este género.
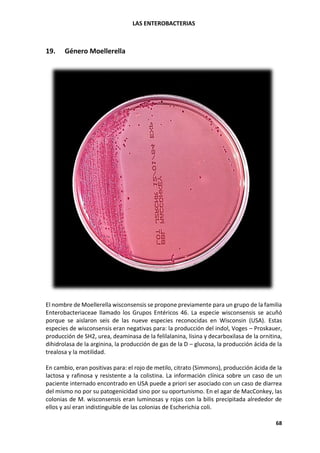
LAS ENTEROBACTERIAS
68
19. Género Moellerella
El nombre de Moellerella wisconsensis se propone previamente para un grupo de la familia
Enterobacteriaceae llamado los Grupos Entéricos 46. La especie wisconsensis se acuñó
porque se aislaron seis de las nueve especies reconocidas en Wisconsin (USA). Estas
especies de wisconsensis eran negativas para: la producción del indol, Voges – Proskauer,
producción de SH2, urea, deaminasa de la felilalanina, lisina y decarboxilasa de la ornitina,
dihidrolasa de la arginina, la producción de gas de la D – glucosa, la producción ácida de la
trealosa y la motilidad.
En cambio, eran positivas para: el rojo de metilo, citrato (Simmons), producción ácida de la
lactosa y rafinosa y resistente a la colistina. La información clínica sobre un caso de un
paciente internado encontrado en USA puede a priori ser asociado con un caso de diarrea
del mismo no por su patogenicidad sino por su oportunismo. En el agar de MacConkey, las
colonias de M. wisconsensis eran luminosas y rojas con la bilis precipitada alrededor de
ellos y así eran indistinguible de las colonias de Escherichia coli.
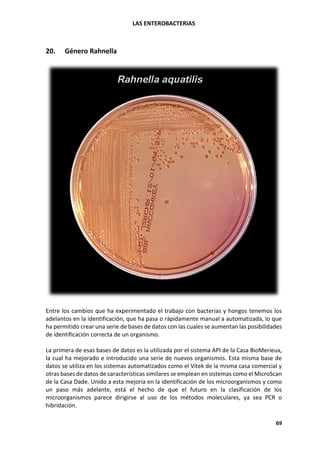
LAS ENTEROBACTERIAS
69
20. Género Rahnella
Entre los cambios que ha experimentado el trabajo con bacterias y hongos tenemos los
adelantos en la identificación, que ha pasa o rápidamente manual a automatizada, lo que
ha permitido crear una serie de bases de datos con las cuales se aumentan las posibilidades
de identificación correcta de un organismo.
La primera de esas bases de datos es la utilizada por el sistema API de la Casa BioMerieux,
la cual ha mejorado e introducido una serie de nuevos organismos. Esta misma base de
datos se utiliza en los sistemas automatizados como el Vitek de la misma casa comercial y
otras bases de datos de características similares se emplean en sistemas como el MicroScan
de la Casa Dade. Unido a esta mejoría en la identificación de los microorganismos y como
un paso más adelante, está el hecho de que el futuro en la clasificación de los
microorganismos parece dirigirse al uso de los métodos moleculares, ya sea PCR o
hibridación.

Este documento describe las características de las enterobacterias. Son bacilos gram negativos que habitan normalmente en el tracto intestinal humano y animal. Algunas especies como Escherichia coli forman parte de la flora normal, mientras que otras como Salmonella y Shigella pueden causar enfermedades. Las enterobacterias se identifican mediante pruebas bioquímicas como la fermentación de azúcares y la producción de enzimas. Juegan un papel importante en infecciones nosocomiales y del tracto urinario.

![LAS ENTEROBACTERIAS
72
✓ MCKAY, A.L. AND PETERS, A.C. 1995. The effect of sodium chloride concentration
and pH on the growth of Salmonella typhimurium colonies on solid medium. J. Appl.
Bacteriol. 79:353-359.
✓ RODRÍGUEZ-JEREZ, J.J.; ROIG-SAGUES, A.X.; MORA-VENTURA, M.T.; GARCIA-
MAROTO, A. AND ALVAREZ-QUINTANA, M.A. 1996. A comparison between
traditional plating methods, VIDAS system and Bactometer for rapid detection of
Salmonella in poultry. 16th International Symposium of the International
Committee on Food Microbiology and Hygiene. Budapest (Hungary). 1996.
✓ I.C.M.S.F. 1983. Ecología microbiana de los alimentos. Vol. I. Factores que afectan a
la supervivencia de los microorganismos en los alimentos. Acribia. Zaragoza
✓ EICKHOFF, T.C. 1972. Infección de los pneumoniae del Klebsiella: una revisión
referente a la significación epidemiológica flotante de la presencia de los
pneumoniae del K. en el ambiente natural. Consejo nacional de la industria de papel
para Air y boletín técnico no 254, Nueva York, N.Y. de Stream Improvement, Inc.
✓ MARTIN W.J., P., K.W. YU, Y J.A. Washington. 1971. Significación epidemiológica de
los pneumoniae del Klebsiella - un estudio de 3 meses. Mayo C.in. Proc. 46:785 -
793. 3) SELDEN, R., HECES DEL S., W.L.L. WANG, J. V. BENNETT Y T.C. EICKHOFF.
1971. Infecciones nosocomiales del Klebsiella: colonización intestinal como
resevoir. Anuncio Interno. Med. 74:657 - 664.]
✓ PATTERSON Y M.J. WOODBURN, 1980. Diario de la ciencia de alimento 45:492 - 495
y D.F. SPLITTSTOESSER, D.T. QUEALE Y B.W. ANDALORO. 1983. La microbiología de
los brotes vegetales durante la producción comercial. Diario de la seguridad 5:79 -
86 del alimento.
✓ SORIANO JM, RICO H, MOLTO JC, MELENAS J., Microbiología interna del alimento
de J 2000 30 Jun; 58 (1-2): 123-8, Gravamen de la calidad microbiológica y
tratamientos de la colada de la lechuga servidos en restaurantes de la Universidad
– Comunicación Personal TERRY PETERS, Salud – Canadá.
✓ Recomendaciones del Comité de Nefrología de la Sociedad Argentina de Pediatría
para la prevención del Síndrome Urémico Hemolítico (febrero 1999).
✓ Síndrome Urémico Hemolítico: Estudio anatomo clínico de 59 pacientes. G.GALLO,
F. MENDILAHARZU Y N. DELGADO.
✓ Oficina de Prensa y Comunicación Ministerio de Salud de la Nación.
✓ Comité de Nefrología. Incidencia del Síndrome Urémico Hemolítico (SUH) en la
República Argentina. Arch Arg Pediatr 1995; 93: 409-11.
✓ DRA. MARTA RIVAS, Servicio de Fisiopatogenia, INEI – ANLISMALBRAN.
✓ Ciencia y Técnica UNL - Fuente: Prensa Institucional UNL) - Importancia del
diagnóstico precoz del Síndrome Urémico Hemolítico.
✓ LABORATORIO ELEA SACIFYA. Gallo 238 PB - Buenos Aires – Argentina.
✓ MARÍA ROSA VIÑAS, MARCELO E. SANZ, NORA L. PADOLA, ANALÍA I. ETCHEVERRÍA,
ALBERTO E. PARMA - Laboratorio de Inmunoquímica y Biotecnología, Facultad de
Ciencias Veterinarias Universidad Nacional del Centro y CIC, Tandil - Escherichia coli
verotoxigénica (VTEC): su transmisión por alimentos – Ciencia Hoy Volumen 10 Nro.
55 - Febrero / Marzo 2000.
✓ 46 SANZ, M. E., VIÑAS, M. R. & PARMA, A. E., 1997, "Prevalencia de E. coli
verotoxigénica (VTEC) en bovinos de Argentina". Libro de resúmenes del I Congreso
Internacional de Infectología y Microbiología Clínica (SADI-SADEBAC), E53.](https://image.slidesharecdn.com/bagginisantiagopablo-lasenterobacterias-210509193117/85/Dr-Santiago-Pablo-Baggini-72-320.jpg)

